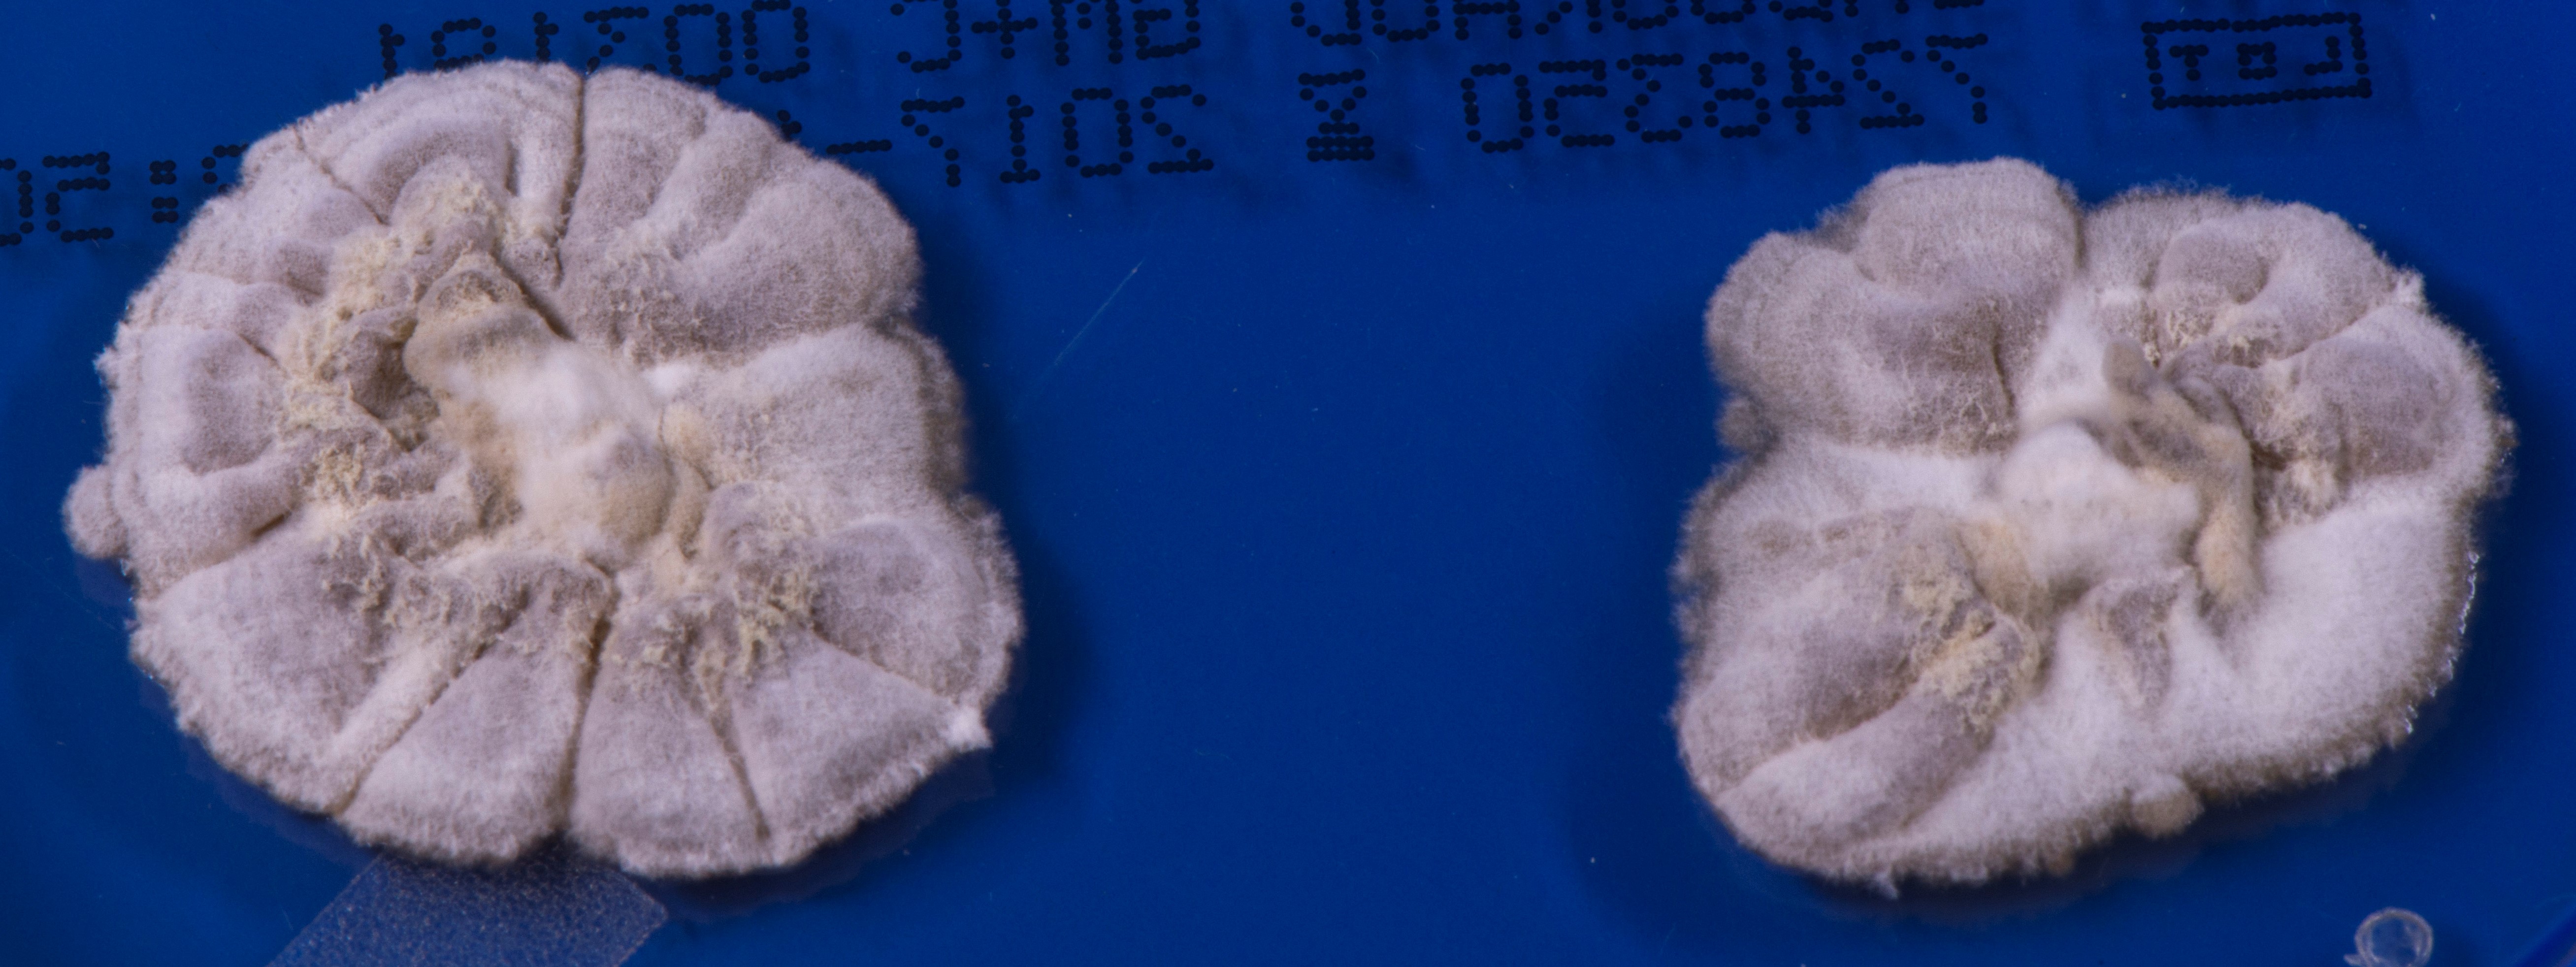
None

Arthroderma chiloniense Brasch 2018
Entsprechend der neuen Taxonomie der Dermatophyten werden in der Gattung Arthroderma (A.) ausschließlich geophile Pilzarten zusammengefasst.
Bekannte Arthroderma-Arten sind A. ciferrii, A. insingulare, A. gertleri, A. onychocola, A.phaseoliforme, A. quadrifidum, A. redellii, A. tuberculatum, A. uncinatum, A. thuringiensis, daneben gibt es neue Spezies wie A. amazonicum, A. crocatum, A. eboreum und A. vespertilii.
Im Jahr 2019 wurde der zuerst in Kiel isolierte neue geophile Dermatophyt A. chiloniense beschrieben.
Obwohl der Pilz ausnahmslos vom Menschen unter dem Verdacht auf eine Dermatophytose der Haut oder der Nägel isoliert wurde, ist bisher unklar, ob A. chiloniense überhaupt pathogenes Potential besitzt oder nur als saprophytärer Pilz passager die Haut und Nägel besiedelt.